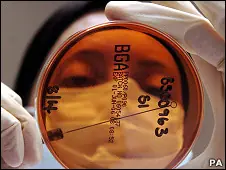
Super bacteria causa preocupación.

quempachy
Usuario (Argentina)
Un parche que se coloca en la piel y suministra una vacuna sin necesidad del doloroso pinchazo de una aguja fue desarrollado por científicos en Estados Unidos. Según los investigadores, el parche -que cuenta con cientos de agujas microscópicas que se disuelven en la piel- demostró mejorar la efectividad de inmunizaciones como la influenza. Las pruebas llevadas a cabo con ratones mostraron que la tecnología puede producir una mejor respuesta inmune que una vacuna convencional. Según los científicos, que publican el avance en la revista Nature Medicine, el parche podría eventualmente permitir que la gente se inocule a sí misma, lo cual podría ayudar a prevenir muchas enfermedades y salvar vidas. Mejor inmunización La tecnología, desarrollada por investigadores de la Universidad de Emory y el Instituto de Tecnología de Georgia, contiene 100 "microagujas" que miden solo 650 micrómetros (0.065 milímetros) de largo. Éstas están diseñadas para penetrar las capas superiores de la piel disolviéndose al hacer contacto. Para probar la tecnología los investigadores cargaron las agujas con una vacuna de influenza. Un grupo de ratones recibió la inoculación utilizando agujas hipodérmicas tradicionales y otro grupo fue inoculado con el parche. Imaginamos que la gente podrá obtener el parche por correo o en una farmacia y después autoadministrárselo en casa Prof. Sean Sullivan Un tercer grupo de animales recibió un parche que no tenía compuesto activo. Tres meses después, cuando los animales habían sido infectados con el virus de gripe, el equipo descubrió que el parche produjo una respuesta inmune más efectiva que la inoculación estándar. "La piel es un sitio particularmente atractivo para la inmunización porque contiene una abundancia de tipos celulares que son importantes para generar una respuesta inmune a las vacunas", explica el profesor Richard Compans, de la Universidad de Emory. Según los científicos, si se demuestra que el parche es efectivo en las pruebas con humanos, esto podría significar el fin de la necesidad de entrenamiento médico para suministrar vacunas. Además, la tecnología podría convertir a la inmunización en un procedimiento indoloro que la gente podría llevar a cabo sola. También simplificaría los programas de vacunación a gran escala durante una pandemia y eliminaría los temores del uso estéril aguas hipodérmicas y el problema de su desecho. Autoadministrada "Otra ventaja de estas microagujas es que la vacuna está presente en una fórmula seca, lo cual mejora su estabilidad durante la distribución y almacenamiento", dice la profesora Ioanna Skountzou, otra de las investigadoras. El parche cuenta con agujas microscópicas que administran la vacuna en la piel. Aunque el estudio sólo analizó la respuesta de una vacuna de influenza, se espera que la tecnología pueda ser utilizada también con otras inmunizaciones. Y el parche no sería más costoso que las vacunas con agujas tradicionales. "Imaginamos que la gente podrá obtener el parche por correo o en una farmacia y después autoadministrárselo en casa", afirma el profesor Sean Sullivan quien dirigió el estudio en el Instituto de Tecnología de Georgia. "Debido a que las microagujas del parche se disuelven en la piel no quedan restos peligrosos de agujas puntiagudas", agrega. Las microagujas están hechas de un material polímero, llamado polivinilpirrolidona o PVP, que se disuelve en el agua y que ha demostrado ser seguro para uso en el organismo humano. Los investigadores creen que la tecnología podría ser una herramienta muy útil principalmente en los países en desarrollo donde la pobre infraestructura médica a menudo provoca la reutilización de agujas hipodérmicas, lo que contribuye a la propagación de enfermedades como VIH y hepatitis B. Tal como explica el profesor Compans, la vacuna no tiene que penetrar profundamente en la piel porque las células inmunes están presentes justo debajo de la superficie. Todavía, sin embargo, hace falta llevar a cabo más ensayos clínicos para demostrar la seguridad y efectividad de la tecnología en el ser humano. Fuente: http://www.bbc.co.uk/mundo/ciencia_tecnologia/2010/07/100719_parche_vacuna_men.shtml
No son como las que usan las estrellas pero sus creadores aseguran que puede ser la solución más rápida y económica a los defectos de la vista, un problema que afecta a millones de personas en todo el mundo. Se trata de unos anteojos que permiten al usuario corregir su deficiencia óptica sin necesidad de acudir al consultorio del oftalmólogo. ''Es un producto mecánicamente simple y que puede ser manejado por cualquier persona, de manera que podría ayudar a mejorar la vida de millones de personas, particularmente en los países en desarrollo, donde no es fácil tener acceso a un especialista óptico'', le explica a BBC Mundo, Jan in 't Veld, miembro del consejo directivo de Focus on Visión, la Fundación holandesa que promueve el uso de estas gafas. Los anteojos se llaman Focusspec y consisten en dos lentes deslizables que permiten alterar las variables ópticas y que se van ajustando por medio de un ingenioso dispositivo giratorio que se encuentra en cada uno de los lados de las gafas. Así, el paciente puede corregir de forma independiente la visión de sus ojos izquierdo y derecho. La focalización de los cristales varía entre +0.5 y +4.5 dioptras por una parte y -1 a -5 dioptras por la otra. Los cristales son resistentes al polvo, la humedad y los rayos UV, y el armazón se ajusta fácilmente al usuario al seguir un diseño que ha sido realizado con base a mediciones promedio de la cabeza de niños y adultos. La invención tiene sus orígenes en un principio científico desarrollado en la década de los '60 por el científico nuclear estadounidense y ganador del Premio Nobel, Luis Álvarez, y que consistió en modificar el foco por medio de dos lentes deslizables. Enfocando la expansión Las primeras 40.000 unidades se han repartido en países como Afganistán y Tanzania, y algunos miles de pares han llegado a Panamá, Venezuela, Guatemala y Honduras. Quien no ve bien, se los pone y los ajusta hasta lograr una visión clara. ''Anticipamos un importante crecimiento en Latinoamérica, debido a que en los países en desarrollo es más difícil tener acceso a un oculista'', sostiene Jan in 't Veld. El experto, pone de ejemplo el caso de Tanzania, donde hay 15 oftalmólogos para los 40 millones de habitantes, mientras que en los países de la Unión Europea hay uno por cada 25.000 personas. En Honduras, Nicaragua, Guatemala, El Salvador y Bolivia, se estima que hay entre 5 y 15 oftalmólogos por cada millón de habitantes, según las últimas estadísticas de la Organización Panamericana de la Salud, la oficina regional de la Organización Mundial de la Salud. ''Este instrumento puede cambiarles la vida, no sólo podrán mejorar su visión, sino hacer cosas simples como insertar un hilo en una aguja'', dice Jan in 't Veld. Un camino borroso A pesar de que los científicos de Focus on Visión desarrollaron su primer modelo de anteojos autoajustables en diciembre 2003, el artículo apenas comienza a llegar al mercado. La introducción del instrumento óptico ha enfrentado una serie de dificultades. Se teme que los niños dañen su vista si los ajustan mal o si juegan con los cristales de aumento. Existe por ejemplo, la preocupación de que pueda tener efectos contraproducentes en los niños, ya que temen que dañen su vista si ajustan mal sus anteojos o si juegan con los cristales de aumento. Al interior de la Organización Mundial de la Salud domina la opinión de que cada anteojo debe ser controlado por un optometrista calificado, lo que supone un obstáculo para los modelos autoajustables. Otros obstáculos para su desarrollo son la presencia de elevados impuestos a las importaciones de estos objetos y el factor precio. Si bien el precio puede variar de 1 a 3 euros la pieza, se requiere un pedido de 50.000 unidades para garantizar su bajo costo Fuente: http://www.bbc.co.uk/mundo/cultura_sociedad/2010/08/100720_gafas_tercer_mundo.shtml
Esta vez, la cosa parece ir más en serio que nunca hasta ahora. De hecho, ninguno de los más de 500 planetas extrasolares descubiertos hasta el momento reúne las excepcionales condiciones que se dan en Gliese 581g, un mundo que tiene tres veces la masa de la Tierra (suficiente para sustentar una atmósfera) y que se encuentra justo en el centro de la zona de habitabilidad de su estrella, es decir, dentro de la estrecha franja orbital que permite la existencia de agua en estado líquido. El hallazgo, que puede marcar un antes y un después en la búsqueda de «nuevas Tierras», acaba de ser anunciado por un equipo de astrónomos de las Universidades de California y Santa Cruz y del Instituto Carnegie de Washington y será publicado próximamente en Astrophysical Journal. Si los datos se confirman, el nuevo mundo sería el más parecido al nuestro de todos los que se han descubierto hasta ahora. Tanto, que podría albergar agua y reunir las condiciones necesarias para ser habitable. Sin embargo, el mero hecho de que Gliese 581g sea considerado capaz de sustentar vida no significa necesariamente que sea un lugar agradable para vivir en él. La habitabilidad de un planeta depende de numerosos factores, y las variables necesarias pueden variar mucho de una a otra zona dentro de un mismo mundo. Sin ir más lejos, aquí, en la Tierra, existen numerosos entornos en los que, a pesar de que existe la vida, los seres humanos no podrían vivir. Lo realmente importante de Gliese 581g es que reúne, por primera vez, las dos condiciones más importantes que se consideran necesarias para que la vida pueda existir: la posibilidad de agua en estado líquido y la presencia de una atmósfera que retenga los gases necesarios. Muchos más como éste «Nuestros hallazgos -asegura Steven Vogt, profesor de Astronomía y Astrofísica de la Universidad de Santa Cruz- suponen un caso muy convincente de planeta potencialmente habitable. Y el hecho de que hayamos sido capaces de detectar este planeta tan rápidamente y tan cerca de nosotros nos dice que los mundos como éste deben ser realmente comunes». El nuevo planeta se encuentra a 20 años luz de la Tierra, alrededor de una estrella, Gliese 581, muy bien conocida por los cazadores de planetas. De hecho, con éste ya son seis los mundos descubiertos en órbita de esta enana roja. Los hallazgos se basan en el análisis de once años de observaciones del observatorio Keck, en Hawaii. Para Paul Butler, del Instituto Carnegie, la combinación de nuevas técnicas y grandes telescopios terrestres sigue liderando claramente la revolución de los exoplanetas. «Ahora -afirma el astrónomo- el único límite a nuestra capacidad para encontrar mundos potencialmente habitables es el tiempo que tengamos asignado el telescopio». En realidad, son dos los nuevos planetas que el equipo de astrónomos ha descubierto alrededor de Gliese 581, lo que eleva a seis el número total de mundos que orbitan esta enana roja. Pero el más interesante es, sin duda, el «g», con una masa entre tres y cuatro veces la de la Tierra y un periodo orbital de 36,6 días. Su masa indica que, con toda probabilidad, se trata de un mundo rocoso, como el nuestro, con una superficie bien definida y con una gravedad suficiente para retener su propia atmósfera. Planetas cercanos No es la primera vez que se anuncia el descubrimiento de un mundo potencialmente habitable alrededor de esta pequeña estrella. En efecto, otros dos planetas de este sistema se encuentran en las fronteras mismas de la zona de habitabilidad de Gliese 581 y suscitaron, al ser descubiertos, el entusiasmo de la comunidad científica. Sin embargo, ninguno de los dos ofrece plenas garantías: uno de ellos (el planeta «c») está en el «borde caliente» (más próximo a la estrella) de la zona habitable; y el otro (el planeta «d»), se encuentra en el «borde frío». Ambos, por lo tanto, ofrecen a los científicos dudas más que razonables sobre sus condiciones de habitabilidad. Pero el caso del planeta recién descubierto es muy diferente: «g» está justo en medio de la zona de habitabilidad. En nuestro propio Sistema Solar, el centro de la zona habitable está ocupado por la Tierra, y las fronteras caliente y fría por Venus y Marte, respectivamente. El primero es un planeta tórrido, el segundo un mundo helado. En Gliese 581, explica Vogt, «tenemos planetas en los dos lados de la zona habitable, uno demasiado frío y otro demasiado caliente, y ahora tenemos uno justo en el medio, que es lo correcto». Noche perpetua Otra peculiaridad del nuevo mundo es que, debido a las fuerzas de marea y a la distancia a la que se encuentra de su estrella, es más que probable que muestre siempre la misma cara a su sol, de la misma forma en que la Luna muestra siempre la misma cara a la Tierra. Lo cual significa que la mitad del planeta vive permanentemente de día y la otra mitad está sumido en una noche perpetua. Los investigadores estiman que las temperaturas medias de Gliese 581g oscilan entre los -31 grados en el lado oscuro y los -10 en la cara iluminada. Y para Vogt, la zona más favorable para la vida de todo el planeta es precisamente la que está a ambos lados de la línea que separa la luz de la sombra (llamada «terminador»), con temperaturas que van disminuyendo a medida que nos acercamos a la zona nocturna y que van aumentando al acercarse a la zona diurna. «Cualquier forma de vida tendría un amplio rango de climas estables para elegir dónde asentarse», opina Vogt. Fuente: http://www.abc.es/20100930/ciencia/blog-nieves-201009300754.html
Científicos británicos instaron este miércoles a realizar un esfuerzo internacional para enfrentar un nuevo tipo de bacteria hospitalaria, capaz de resistir a los antibióticos más poderosos. Los investigadores creen que las súperbacterias que producen la enzima NDM-1 ya están bastante extendidas en la India y Pakistán, pero también se ha detectado su presencia en el Reino Unido, probablemente acarreada por personas que se sometieron a cirugías en esos países. Otros casos también han sido reportados en Estados Unidos, Canadá, Australia y Holanda, lo que hace temer que pueda convertirse en un problema global. Los científicos afirman en un artículo publicado en la revista The Lancet Infectious Diseases que, para evitar que ello ocurra, es necesaria mayor vigilancia internacional, así como el desarrollo de nuevos medicamentos. En el sistema digestivo El NDM-1 se encuentra por lo general en el sistema digestivo y puede existir dentro de otras bacterias, como la Escherichia coli, haciéndolas resistentes a los antibióticos más poderosos, conocidos como carbapenems. Los científicos temen que pueda saltar a otras bacterias que ya son capaces de resistir a muchos otros antibióticos, lo que podría hacer cada vez más difícil el tratamiento de infecciones intrahospitalarias. Para evitar que el NDM-1 se propague, dicen los investigadores, hay que identificar y aislar rápidamente a los pacientes infectados. Medidas sencillas como desinfectar los equipos médicos y garantizar que médicos y enfermeras se laven las manos con jabón antibacteriano también ayudan. Como explica la especialista en temas de salud de la BBC, Michelle Roberts, por el momento la mayoría de las bacterias que cargan al NDM-1 han podido ser tratadas usando una combinación de diferentes antibióticos. El potencial para que el NDM-1 se convierta en endémico en el nivel mundial, sin embargo, "es claro y preocupante", dice el artículo en la revista médica británica The Lancet. El estudio fue llevado a cabo por la Universidad de Cardiff, en Gales, la Agencia de Protección Sanitaria del Reino Unido y varios colegas internacionales. Fuente: http://www.bbc.co.uk/mundo/ciencia_tecnologia/2010/08/100811_alerta_super_bacteria_aw.shtml

link: http://www.youtube.com/watch?v=j1ehKY35IkA Científicos británicos crearon un nuevo tipo de material textil que no requiere de costuras para crear ropa: una tela que puede aplicarse directamente sobre el cuerpo desde la lata de aerosol. Además del diseño de modas, las aplicaciones de este nuevo textil incluyen también vendajes médicos y cubiertas para muebles. La tela en aerosol se seca de forma instantánea y puede lavarse y volverse a utilizar. El material fue creado por el diseñador de modas español Manuel Torres y el profesor Paul Luckham del Departamento de Ingeniería Química del Imperial College de Londres. El diseñador presentará su colección de ropa hecha con aerosol durante la semana de la moda en Londres, el próximo lunes. Fibras aglomeradas La nueva tela consiste de fibras cortas que se combinan con polímeros para aglomerarlas, y un solvente que libera el material en forma líquida y se evapora cuando el aerosol alcanza la superficie. El aerosol puede aplicarse utilizando una pistola atomizadora de alta presión o una lata de aerosol. Según los investigadores, la textura de la tela puede cambiarse dependiendo del tipo de fibra que se utiliza, como lana, lino o acrílico, y de cuántas capas de aerosol se apliquen. El material puede tener distintas propiedades, dependiendo del uso que se le quiera dar, y también pueden crearse distintos patrones o aplicar distintos colores. La tecnología, afirma el profesor Paul Luckham puede tener varios usos además de la moda. Por ejemplo, puede utilizarse para crear parches o vendajes médicos, toallas higiénicas, aromatizante para ambientes y material de tapicería para muebles y autos. "La aplicación de la tela en aerosol en el campo de la moda es una gran forma de anunciar este concepto" afirma el profesor Luckham. "Pero también queremos trabajar en nuevas aplicaciones para la medicina, el transporte y las industrias químicas". "Por ejemplo, la tela en aerosol podría producirse de forma esterilizada y mantenerla así en la lata, lo cual sería perfecto para vendajes de emergencia con los cuales no habría necesidad de ejercer presión, como en piel quemada, o para aplicar medicamento directamente sobre la herida". . La idea del material surgió cuando Manuel Torres estudiaba en el Real Colegio de Arte en Londres y su investigación fue supervisada por el profesor Luckham. Posteriormente, ambos decidieron establecer la compañía Fabrican para estudiar otras posibles aplicaciones de esta tecnología. "Cuando comencé este proyecto realmente quería crear un material futurista, que no requería de costuras, que fuera rápido y cómodo", afirma Manuel Torres. "En mi búsqueda para producir este tipo de tela, terminé volviendo a los principios de los textiles más antiguos, como el fieltro, que también fue creado con fibras y buscando la forma de aglomerarlas sin tener que tejerlas o coserlas". "Como artista paso el tiempo soñando creaciones originales, pero como científico tengo que centrarme en cómo poder reproducir esas cosas". "Lo que intento es demostrar cómo la ciencia y la tecnología pueden ayudar a los diseñadores a crear nuevos materiales" expresa el diseñador. Fuente: http://www.bbc.co.uk/mundo/ciencia_tecnologia/2010/09/100916_ropa_aerosol_men.shtml
¿Quién dijo que el tamaño no importa? Cuando se trata de vacas o mejor dicho sobre el efecto nocivo del gas metano que producen sobre el medio ambiente, cuanto más pequeñas, mejor. Ésta parece ser la máxima que se está imponiendo en algunas granjas de Estados Unidos, donde está creciendo la tendencia a criar vacas en miniatura. Existen cerca de 26 razas de minivacas en todo el mundo, las más altas apenas superan el metro y las hay incluso de menos de 80 centímetros. "Cuando comencé a probar con estas reces en miniatura, todo el mundo pensó que estaba loco", le cuenta a BBC Mundo el profesor y granjero Richard Gradwohl, quien en su centro de investigación desarrolló 18 de estas 26 variedades. Y aunque su objetivo inicial fue crear estos animales con el fin de suplir las necesidades de siete mercados diferentes -de los cuales el de las mascotas sigue siendo el más popular- muy pronto notó los beneficios ambientales de las miniaturas. "Después de investigar durante muchos años, descubrimos que producen mucho menos metano", afirma Gradwohl. El metano es uno de los varios gases con efecto invernadero que contribuyen al cambio climático. Según explica Gradwhol, diez minivacas generan la misma cantidad de este gas que una grande. Menos terreno mas carne! "Por otra parte, en un terreno de cinco hectáreas, en el que caben dos vacas, entran diez minivacas", dice. De ahí se desprende que cada hectárea tiene un rendimiento mayor por kilo de carne. ¿Cómo es posible si las vacas son más pequeñas? Esto se debe a una serie de factores y en particular a que la relación entre el peso del animal vivo y la cantidad de carne comestible que se obtiene de él no es la misma en un animal grande que en uno pequeño. "Cuando una vaca de 450 kilos va al matadero pierde cerca del 40% en huesos, cabeza y órganos internos. Queda entonces una res de 270 kilos. Cuando la conviertes en carne comestible pierdes otro 20% y, finalmente, terminas con algo así como 216 kilos", explica Gradwohl. "En una animal pequeño se pierde mucho menos. Si la vaca pesa unos 270 kilos, cuando va al matadero en vez de perder el 40%, pierde el 30% y cuando conviertes lo que queda en carne comestible, en vez del 20%, pierdes el 15%. Entonces, un animal pequeño puede producir hasta 160 kilos de carne comestible", dice el granjero. Estos porcentajes son menores porque las vacas en miniatura tienen huesos más pequeños y menos cantidad de grasa. Como carne de ternera Al aumentar el rendimiento por hectárea, los ranchos necesitan menos terreno para producir la misma cantidad de carne. Esto es crucial, sobre todo en áreas donde el avance de la agricultura y la ganadería son las principales causas de la deforestación. En cuanto al sabor, Gradwohl argumenta que la carne de minivaca es aún más sabrosa, ya que el gusto está relacionado con la longitud de los músculos. "Cuanto más cortos, más rica es la carne. En ese aspecto es parecida a la carne de ternera", señala. En Estados Unidos -donde el consumo anual de carne vacuna por persona es de 43 kilos- ya hay unas 20.000 miniaturas. Sería interesante ver si la moda prende en otros países, como Uruguay o Argentina, donde el consumo de carne per cápita asciende a 58,2% (el país que más consume por persona en el mundo) y 56,2%, respectivamente. Fuente: http://www.bbc.co.uk/mundo/ciencia_tecnologia/2010/08/100813_vacas_mini_metano_lp.shtml
El hombre al que le crecieron arvejas en el pulmón Un estadounidense ingresó en un hospital en Massachusetts con una crisis respiratoria y regresó a su casa con un diagnóstico inusual: le crecía una planta de arvejas en el pulmón. Ron Sveden luchaba contra un enfisema desde hacía meses y, con un neumotórax, su estado de salud se había deteriorado. Cuando se temía que las pruebas a las que lo sometían terminaran por revelar un diagnóstico de cáncer, los rayos X pusieron en evidencia la extraña causa de sus problemas. "Creo que lo que bueno para mí es que al final no era cáncer", dijo Sveden a un canal de televisión de Boston. Explicación La explicación que encuentran los médicos es que el hombre comió guisantes, uno se escapó por "el camino errado" y germinó. "Una de las comidas que tomé en el hospital después de una cirugía tenía arvejas. Me reí y me las comí", declaró Sveden entre risas. Además, bromeó con que de haber seguido creciendo hubiera terminado trabajando para el ogro de "Las habichuelas mágicas", el cuento del danés Hans Christian Andersen. Según el propio Sveden, la planta medía 1,25 centímetros. Fuente: http://www.bbc.co.uk/mundo/ciencia_tecnologia/2010/08/100812_arvejas_pulmon_az.shtml
Los perros imitan de forma automática los movimientos corporales de sus dueños, según una nueva investigación. Los científicos diseñaron una prueba en la que el perro debía abrir una puerta como su dueño. En los humanos, afirman los científicos, esta imitación es una parte crucial del aprendizaje social. Es decir, la gente de forma inconsciente copia los gestos de los individuos que la rodean. Por ejemplo un bostezo o una persona mirando al cielo, automáticamente provocará que los demás bostecen o miren al cielo. Este fenómeno conocido como "imitación automática" es evidente en muchos otros animales. Y tal como descubrieron los investigadores de la Universidad de Viena, las acciones de los perros también están influenciadas por los humanos. Según el estudio publicado en Proceedings of the Royal Society B (Actas de la Sociedad Real B), el hallazgo ofrece información sobre cómo evolucionó este tipo de aprendizaje. La investigación también revela que la forma en que la gente interactúa y juega con sus perros establece la base para esta capacidad de imitación. Ni innato, ni automático "No es algo espontáneo" explica la doctora Friederike Range, quien dirigió el estudio. "Los perros necesitan mucho entrenamiento para aprenderlo", agrega. La investigadora y sus colegas estudiaron esta capacidad de imitación con una serie de ensayos utilizando una prueba simple para abrir una puerta. El equipo construyó una caja con una puerta deslizable al frente que podía abrirse con una manija. "Cuando los dueños utilizaban la mano, el perro tenía que abrir la puerta con su pata para obtener una recompensa", dice la doctora Range. El fenómeno de "imitación automática" en los perros requiere de entrenamiento. Si el dueño abría la puerta con su boca, el perro tenía que usar la misma técnica. Según explica la investigadora a la BBC "un segundo grupo de perros tenía que aprender el método alternativo, es decir, si el dueño usaba la mano el perro tenía que usar la boca, y cuando el dueño usaba la boca, el perro usaba la pata". Los perros que tenían que usar el primer método aprendieron su tarea mucho más rápido que los que usaban el método alternativo. Esto demuestra que los animales tienen una predisposición a imitar los movimientos de sus dueños, dice Frederike Range. Agrega que, debido a que los perros tienen formas corporales muy diferentes a las de la gente, también deben interpretar lo que están viendo. "Este tipo de aprendizaje tiene ventajas obvias para los animales", señala. "Pueden aprender sobre ciertos aspectos de la vida sin tener que experimentar con "prueba y error", lo cual siempre tiene cierto riesgo". Esta evidencia apoya la teoría de aprendizaje que sugiere que el sistema de "neuronas de espejo" y la capacidad de imitación se forjan cuando el animal aprende y se desarrolla, y no es un proceso innato. Fuente: http://www.bbc.co.uk/mundo/ciencia_tecnologia/2010/07/100729_perros_movimientos_men.shtml

Se llaman «buckybolas» y nunca antes habían sido vistas en el espacio. Se trata de unas moléculas de carbono en forma de balón de fútbol que fueron vistas por primera vez en laboratorio hace 25 años, pero que nunca habían sido detectadas más allá de la atmósfera y cuya existencia ahí arriba, aunque se sospechaba, ha supuesto una auténtica sorpresa. Ahora, el telescopio espacial Spitzer de la NASA las ha descubierto flotando en una nebulosa planetaria conocida como Tc 1. La revista Science publica un artículo sobre el descubrimiento. El profesor japonés Eiji Osawa predijo la existencia de las «buckybolas» en 1970, pero no se observaron hasta quince años después en laboratorio. Desde entonces, estas moléculas se han encontrado en el hollín de las velas, capas de rocas y meteoritos, pero habían sido muy esquivas en el espacio. Llamadas así porque recuerdan a las cúpulas geodésicas del arquitecto Buckminster Fuller, las «buckybolas» son «las moléculas más grandes conocidas en el espacio», asegura el astrónomo Jan Cami, de la Universidad de Ontario Occidental, en Canadá. «Estamos emocionados porque tienen propiedades únicas que las hacen importantes para todo tipo de procesos químicos y físicos que tienen lugar en el espacio», explica. Estos fenómenos están compuestos de 60 átomos de carbono ordenados en estructuras esféricas tridimensionales y son una fotocopia del clásico balón de fútbol. Curiosamente, los científicos también encontraron a unas primas de las «buckybolas», bautizadas como C70, que tienen forma de balón de rugby. Posiblemente, las «buckybolas» reflejan una etapa corta de la vida de la estrella de la nebulosa planetaria en la que se encuentra, cuando desprende grandes cantidades de material rico en carbono. Los científicos reconocen que las descubrieron gracias a un golpe de suerte, ya que dentro de unos años pueden estar demasiado frías para ser detectadas. En la Tierra, el estudio de estas moléculas se aplica a la investigación en fármcos y tecnologías superconductoras. Fuente: http://www.abc.es/20100723/ciencia/descubren-unas-bolas-espaciales-201007231741.html

Un grupo de investigadores de la Escuela de Medicina de la Universidad de Stanford ha desarrollado un nuevo método que permite contemplar, en todo su esplendor y en 3D, el funcionamiento de los circuitos cerebrales con un detalle sin precedentes. El vídeo bajo estas líneas, que muestra la corteza cerebral de un ratón, recorre la impresionante imagen obtenida por los neurólogos. El nivel de detalle es tal, que los investigadores han podido contar sin dificultad las conexiones sinápticas entre las neuronas y distinguir a la perfección entre los diferentes e intricados circuitos cerebrales. Algo que hasta ahora resultaba imposible. Un cerebro humano típico contiene cerca de doscientos mil millones de neuronas, las células nerviosas que, enlazadas unas con otras por medio de billones de conexiones diferentes (las sinapsis), hacen posible el funcionamiento del órgano más complejo del cuerpo. A través de esas sinapsis, los impulsos eléctricos tranportan de una parte a otra del cerebro la información y transmiten las órdenes necesarias a cada parte del organismo. Es así como el cerebro controla cada uno de nuestros movimientos, emociones y pensamientos. Una única neurona puede llegar a realizar varias decenas de miles de contactos sinápticos con otras neuronas, según el estudio recién publicado en Neuron por el profesor de fisiología molecular y celular Stephen Smith. link: http://www.youtube.com/watch?v=-YIYPSAyySg Sin embargo, debido a su reducido tamaño y al hecho de que están estrechamente "empaquetadas" unas junto a otras, resulta extraordinariamente complicado abrirse paso a través de la compleja red de circuitos neuronales para distinguirlos individualmente. Ni siquiera los mejores microscopios ópticos son capaces, hoy por hoy, de desenredar la maraña sináptica y revelar todos sus detalles. Pero la nueva técnica desarrollada por los científicos de Stanford ha superado esta limitación y permite elaborar auténticos "mapas visuales" en los que los neurólogos pueden distinguir con facilidad hasta el menor de los detalles. Filetes de cerebro de ratón El nuevo método, que consiste en obtener láminas de tejido cerebral de apenas unos nanómetros de grosor (un nanómetro es la millonésima parte de un milímetro), requiere la combinación de fotografías de alta resolución, proteínas fluorescentes y una supercomputadora para unir y procesar todo el conjunto de datos generados durante el proceso. Para elaborar su imagen, Smith y su equipo obtuvieron primero una muestra de la corteza cerebral de un ratón y la "filetearon" en láminas de apenas 700 nanómetros de espesor. Las secciones fueron después impregnadas con anticuerpos de 17 proteínas involucradas en los procesos sinápticos y mezcladas con moléculas fluorescentes que brillan en diversas tonalidades al ser iluminadas. Los anticuerpos se fueron añadiendo en grupos de tres, de forma que los diferentes tejidos cerebrales fueron revelándose paulatinamente y en colores diferentes. Se realizaron después cantidades masivas de imágenes en alta resolución durante cada uno de estos procesos de impregnación. Finalmente, todas las fotografías fueron unidas por una supercomputadora en una sola imagen tridimensional, que es la que muestra el vídeo. Resultados impresionantes El resultado es realmente impresionante. Un auténtico mapa que revela la posición exacta de cada sinápsis en la corteza cerebral. Cada color diferente corresponde a una clase diferente de conexión. Una herramienta que, según Smith, nos ayudará a comprender un poco mejor la extraordinaria complejidad del cerebro. "Una sinápsis -explica el científico"- es más parecida a un microprocesador, con su propia memoria de almacenamiento y sus elementos de procesado de información, que a un simple interruptor de encendido y apagado. En efecto, una sóla sinápsis puede contener cerca de mil interruptores a escala molecular. Un único cerebro humano tiene más interruptores que la suma de los que tienen todos los ordenadores, routers y conexiones de internet de la Tierra". fuente: http://www.abc.es/20101124/ciencia/imagenes-impactantes-cerebro-201011240939.html